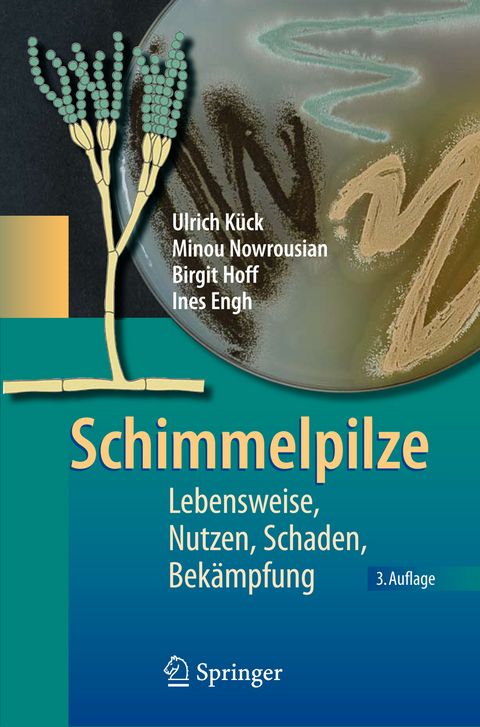
Schimmelpilze - Ulrich K&uuml;ck, Minou Nowrousian, Birgit Hoff, Ines Engh
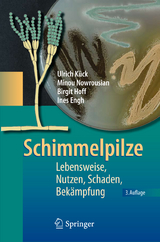
Schimmelpilze - Ulrich K&uuml;ck, Minou Nowrousian, Birgit Hoff, Ines Engh

Schimmelpilze
Springer Berlin (Verlag)
978-3-540-88716-4 (ISBN)
Schimmelpilze - nützlich und schädlich zugleich
Dieses Buch gibt einen umfassenden Überblick über die guten und schlechten Seiten der Schimmelpilze. Nach einer Definition und Einführung in das Thema "Schimmelpilze" erörtern die Autoren deren Biologie, Physiologie und Genetik.
Weiterhin werden der Einsatz von Schimmelpilzen in der Biotechnologie sowie zur Herstellung von Lebensmitteln und bei der biologischen Schädlingsbekämpfung betrachtet. Im Kapitel Schadwirkung und Bekämpfung geht es um die negativen Auswirkungen von Schimmel als Krankheitserreger bei Pflanzen, Tieren und Menschen sowie um die Zerstörungskraft von Schimmelpilzen auf verschiedenen Materialien. Dieses Sachbuch wendet sich an Studierende der Lebenswissenschaften sowie an fachferne Leser, die berufsbedingt mit der Wirkung von Schimmelpilzen befasst sind. Darüber hinaus sollen auch interessierte Laien durch dieses Buch angesprochen werden.
Ein umfassender Überblick zu allen Aspekten von Schimmelpilzen
Einführung.- Biologie.- Physiologie.- Genetik.- Anwendungen.- Schadwirkung und Bekämpfung.
Aus den Rezensionen zur 3. Auflage: "... stellt die zwei Gesichter der Schimmelpilze dar und bietet eine umfassende Übersicht über deren vielfältige Biologie. ... Beispielhaft werden bestimmte von den Pilzen gebildete Stoffklassen und deren Verwendung ... hervorgehoben. Umfangreiche Tabellen bieten einen Überblick über die Vielfalt und Bedeutung der Stoffklassen. ... Die sehr klare und gut verständliche Darstellung, hinterlegt mit farbigen Abbildungen, ist ... für Laien interessant, insbesondere da wichtige biologische Fachbegriffe und grundlegende Vorgänge in Fußnoten und Infoboxen kurz und anschaulich erklärt werden. ... Ein sehr gelungenes Sachbuch mit einem angemessenen Preis-Leistungsverhältnis." (http://www.wissenschaft-online.de/sixcms/detail.php?id=1015187&_druckversion=1)
Aus den Rezensionen zur 3. Auflage:
“... stellt die zwei Gesichter der Schimmelpilze dar und bietet eine umfassende Übersicht über deren vielfältige Biologie. ... Beispielhaft werden bestimmte von den Pilzen gebildete Stoffklassen und deren Verwendung ... hervorgehoben. Umfangreiche Tabellen bieten einen Überblick über die Vielfalt und Bedeutung der Stoffklassen. ... Die sehr klare und gut verständliche Darstellung, hinterlegt mit farbigen Abbildungen, ist ... für Laien interessant, insbesondere da wichtige biologische Fachbegriffe und grundlegende Vorgänge in Fußnoten und Infoboxen kurz und anschaulich erklärt werden. ... Ein sehr gelungenes Sachbuch mit einem angemessenen Preis-Leistungsverhältnis.“ (http://www.wissenschaft-online.de/sixcms/detail.php?id=1015187&_druckversion=1)
| Erscheint lt. Verlag | 5.3.2009 |
|---|---|
| Zusatzinfo | XI, 207 S. |
| Verlagsort | Berlin |
| Sprache | deutsch |
| Maße | 155 x 235 mm |
| Gewicht | 396 g |
| Themenwelt | Naturwissenschaften ► Biologie ► Mikrobiologie / Immunologie |
| Schlagworte | Aspergillus • Biotechnologie • Genetik • Hardcover, Softcover / Biologie/Mikrobiologie • HC/Biologie/Mikrobiologie • Herstellung • Lebensmittel • Lebensmitteltechnologie • Mykosen • Mykotoxin • Pathogenität • Penicillium • Pflanzen • Physiologie • Pilze • Pilzgenetik • Pilz-Systematik • Schimmel • Schimmelpilz • Schimmelpilze • Schimmelpilze / Aspergillus |
| ISBN-10 | 3-540-88716-4 / 3540887164 |
| ISBN-13 | 978-3-540-88716-4 / 9783540887164 |
| Zustand | Neuware |
| Informationen gemäß Produktsicherheitsverordnung (GPSR) | |
| Haben Sie eine Frage zum Produkt? |
aus dem Bereich